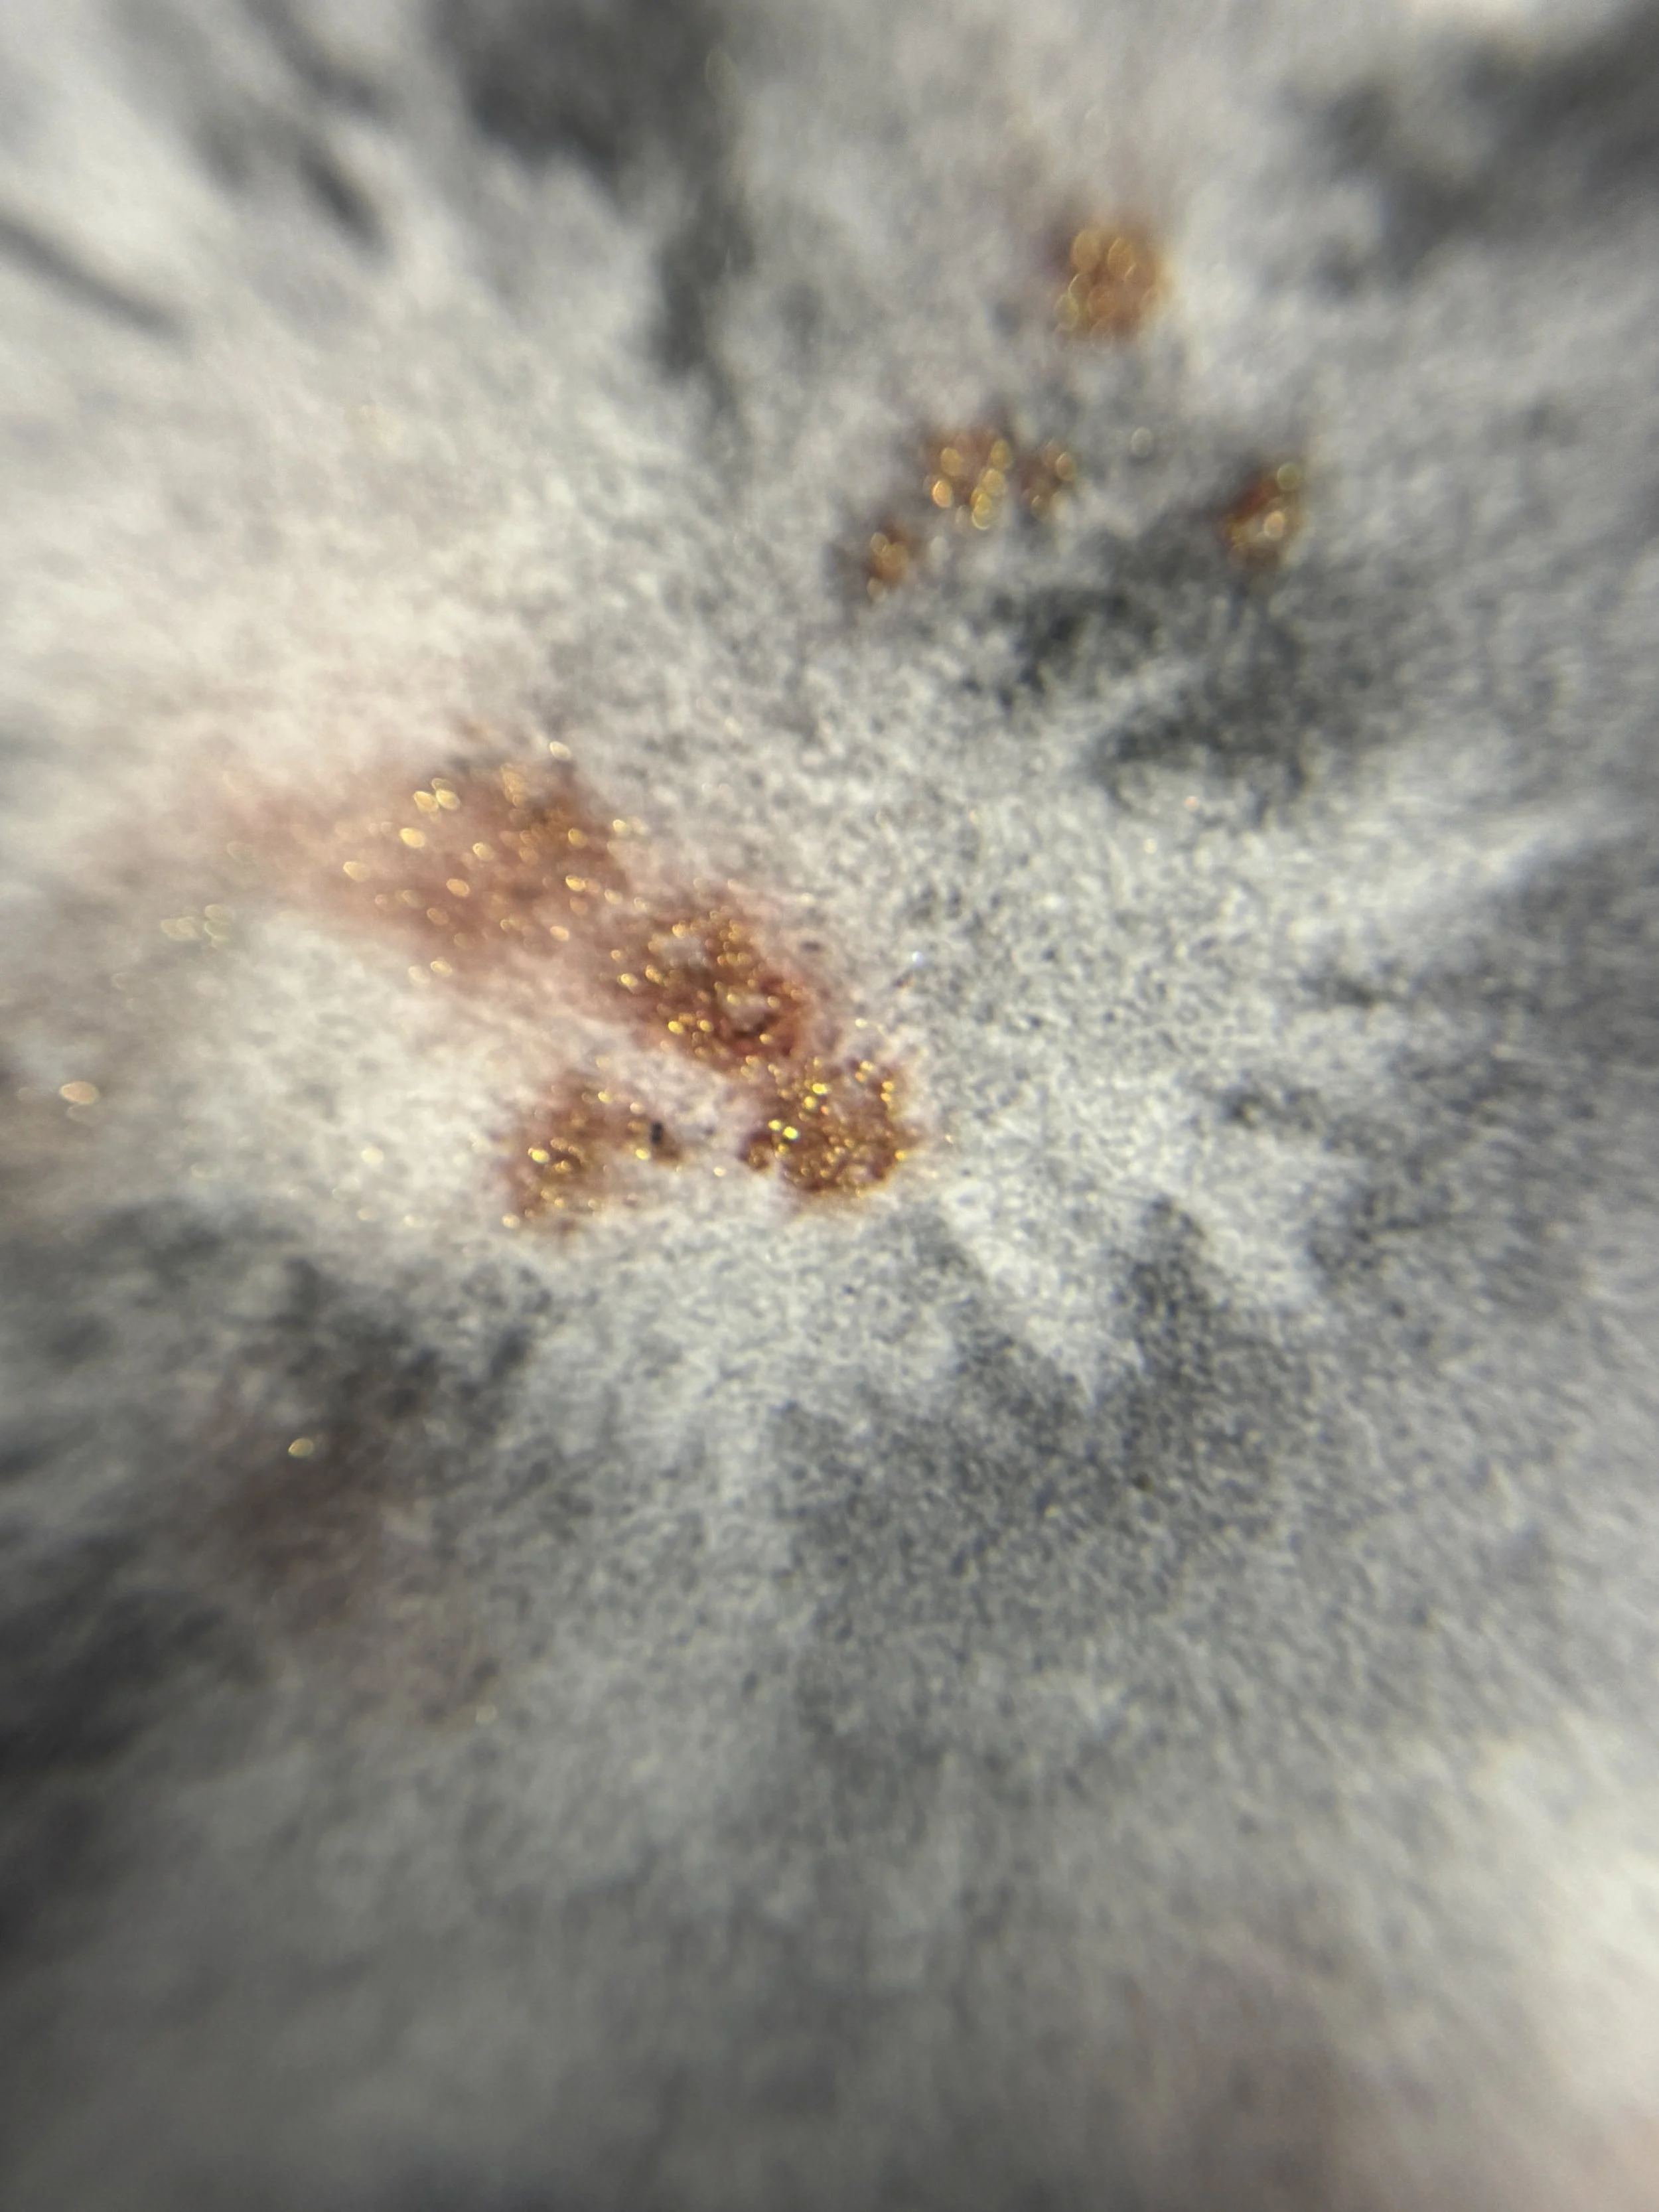
IMG_6269.JPG

Expressing Life’s Beauty, Strength, and Grace through Watercolors and Ink.
About
Drawing and Painting have been apart of my life since I was a kid. If you wanted to distract me all you would have do is give me a piece of paper and a crayon and I would be entertained for hours. As I got older I was inspired by my uncle. His passion and love for art encouraged me to start on my own path as an artist. I am looking forward to many years of learning about the world of art. Creating is a process and a journey I am delighted to be a part of.
Projects
Currently working on my next collection










Collections